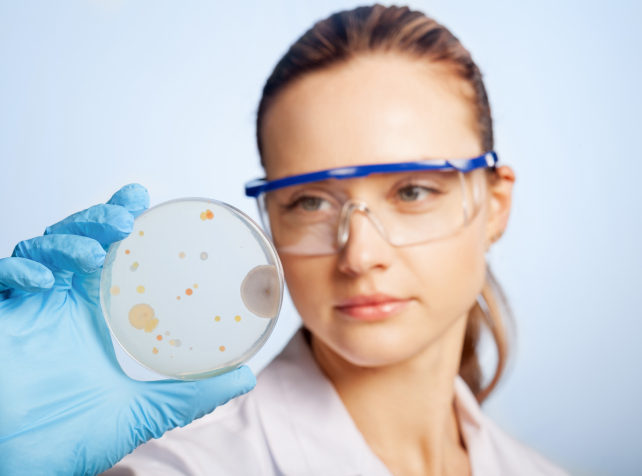
Glimmer of fertility hope in early skin cell exper

Dermatology
-
Glimmer of fertility hope in early skin cell experiment AAP - 05-10-2025
Human skin cells may one day be used to create functional human eggs in a step toward helping women have their own genetic children when their natural eggs are dysfunctional,
-
Rash of allergies costing Australia billions AAP - 28-08-2025
Eating the wrong food could end Harry Norton's life. But instead of being frightened by this daily reality, he says living with allergies is a "bit

-
Rural Australians urged to check skin AAP - 20-06-2022
Cases of melanoma could be going undetected among rural Australians, with those who work on the land prone to falling victim to skin cancer and men more likely than women

-
Monkeypox did not originate from monkeys AAP - 21-05-2022
Health authorities across a number of countries are dealing with small outbreaks of monkeypox. But what is monkeypox and how bad is it? WHAT IS MONKEYPOX?[subscribe]

-
Crocodile meat 'triggers fish allergies' AAP - 20-05-2022
Foodies with a taste for crocodile have been warned eating the apex predator may trigger dangerous food allergies. A new study by James Cook University says

-
Eczema treatment subsidy to help thousands AAP - 24-01-2022
Relief is in sight for Australians faced with bills of almost $30,000 a year as a treatment for a severe type of eczema is listed on the Pharmaceutical Benefits Scheme.

-
Calls for cosmetic surgery regulation AAP - 30-11-2021
More then 300 cosmetic surgeries in Australia have been botched in recent years, prompting calls for tighter regulations for doctors. The Australian Health

-
The 10 things a skin specialist recommends for winter skin Health Times - 17-07-2020
Skin feeling tight, irritated, perhaps flaking and just generally looking dull? Say hello to winter skin! It happens every year and yet we never quite prepare

-
4 1/2 myths about sunscreen and why they're wrong Health Times - 17-01-2020
Many Australians are reluctant to use sunscreen,

-
Numbers count in the genetics of moles and melanomas HealthTimes - 21-08-2019
University of Queensland scientists have identified a way to help dermatologists determine a patient’s risk of developing melanoma. UQ Diamantina Institute

-
Call for greater awareness and understanding of the psychological burden severe eczema has AAP - 12-06-2018
Australians living with severe atopic dermatitis, commonly known as eczema,

-
A new biologic treatment for a debilitating skin disease AAP - 03-07-2017
Dermatologists have welcomed the listing of drug Humira on the PBS, a new biologic treatment for a debilitating skin disease. Australians suffering

-
The Mediterranean diet can reduce ageing of the skin AAP - 10-05-2017
A diet rich in antioxidants can help limit the number of wrinkles you get, Australian dermatologist Dr Michelle Hunt says. The Mediterranean

-
Calls for re-education on the use of steroid creams for children with eczema AAP - 21-02-2017
Editors Comment: This article expresses the view of the President of the Australian College of Dermatologists, and has raised some contention and concern

-
Anti-ageing breakthrough as key enzyme identified AAP - 26-02-2016
UK scientists say the discovery of a key skin cell enzyme will help produce tailored anti-ageing treatments, and could be used in other parts of the body.

-
'Napalm girl' receives laser treatment, 40 years on AAP - 26-10-2015
A new laser treatment is giving hope to scar tissue victims, including Kim Phuc, whose body was burned by Napalm in the Vietnam War. In the

-
Essential vitamin linked to acne AAP - 25-06-2015
The discovery that Vitamin B12 is linked to acne outbreaks could lead to new treatments for the distressing skin disorder. Vitamin B12 may


Article Search
To search for an article, enter a keyword term and click SEARCH
Practice Hubs
For practice specific information, select a field from the list below:


